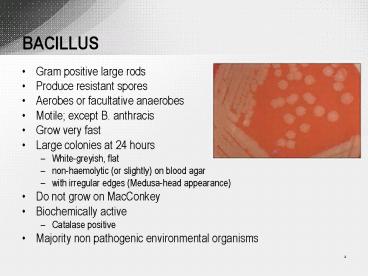

BACILLUS PowerPoint PPT Presentation
1 / 20
Title: BACILLUS
1
BACILLUS
- Gram positive large rods
- Produce resistant spores
- Aerobes or facultative anaerobes
- Motile except B. anthracis
- Grow very fast
- Large colonies at 24 hours
- White-greyish, flat
- non-haemolytic (or slightly) on blood agar
- with irregular edges (Medusa-head appearance)
- Do not grow on MacConkey
- Biochemically active
- Catalase positive
- Majority non pathogenic environmental organisms
2
(No Transcript)
3
Main species of BACILLUS
- B. anthracis - ANTHRAX in cattle, other species
and man - B. cereus food poisoning, eye, soft tissue
infection (man) mastitis (cattle rare) - B. licheniformis sporadic abortion in cattle
and sheep - B. subtilis
- B. stearothermophilus - Used in monitoring
effectiveness of sterilisation (grow up to 75C)
4
Anthrax
- Severe disease affecting virtually all mammalian
species including man - Worldwide, endemic or in defined regions
- Ruminants highly susceptible develop rapidly
fatal septicaemia - Pigs, horses moderately susceptible
- Carnivores comparatively resistant
- Birds almost totally resistant to infection
5
Anthrax - Epidemiology
- Endospore formation most important factor in
persistence of anthrax in environment and spread
to other animals - Endospores survive for decades in soil (up to 50
years) - Outbreaks can occur in herbivores when pasture is
contaminated by spores from buried carcasses - Spores bought to surface by flooding, excavation,
subsidence, earthworm activity - Infection acquired by ingestion of spores
(inhalation, skin abrasion more common in man)
6
Anthrax - Clinical
- Incubation hours days
- Cattle and sheep Septicaemic, rapidly fatal
- Most animals found dead
7
8
Anthrax bacilli occluding the lumen of a blood
capillary. A characteristic of anthrax is the
massive bacteraemia in the last hours of life. At
the point of death, numbers often exceed 108
bacilli/ml blood. (Scanning electron micrograph)
9
Anthrax - Diagnosis
- Carcasses are bloated, putrify and do not exhibit
rigor mortis - Bleeding issues from mouth, nostrils, anus
- If suspected from cattle and sheep, thin blood
smear should be made from blood taken from tail
or ear veins. In horses and pigs, smear can be
made from oedematous fluid, e.g. peritoneal
fluid. - Blood collected from animal stained with
polychrome methylene blue (or Giemsa) blue
bacteria, pink capsules. McFadyeans capsule
stain - Inoculate agar plates for growth
- Characteristic colonial morphology, biochemical
tests - Mucoid colonies on bicarbonate agar, very
susceptible to penecilline, inverted fir tree
type of liquefaction on gelatine stab culture,
and weak lecithinase activity on egg-yolk agar
10
B. anthracis
polychrome methylene blue shows square ended,
blue rods, surrounded by pink capsular material
11
(No Transcript)
12
(No Transcript)
13
(No Transcript)
14
Anthrax - Pathogenesis
- Virulence of B. anthracis derives from presence
of poly-D-glutamic acid capsule and complex
toxin. - Both virulence factors encoded on plasmids and
required for disease. - Expression of these virulence factors regulated
by host temperature and carbon dioxide
concentration. - Capsule inhibits phagocytosis.
- Toxin consists of 3 antigenic components
(protective antigen, oedema factor, and lethal
factor). - PA acts as the binding moiety for both oedema
factor and lethal factor.
15
The mode of action of anthrax toxin. Protective
antigen (PA) binds to host cell-surface receptors
(1) and is cleaved by a cell-surface protease
releasing a 20-kDa piece (2). This exposes a
secondary receptor for the lethal factor (LF) and
edema factor (EF) components of the toxin, which
compete to bind to it (2). The complex is
internalized by receptor-mediated endocytosis (3)
and acidification of the resulting vesicle leads
to the transfer of the LF or EF across the
vesicular membrane into the cytosol where they
effect their catalytic actions (4).
16
Anthrax - Pathogenesis
- Oedema factor is a calmodulin dependent adenylate
cyclase and once inside cells following binding
to PA increases cAMP causing the build up of
fluid in tissue (tissue swells as seen in
clinical disease) - Oedema factor also inhibits neutrophil function,
could be leukocidal - LF stimulates macrophages to release cytokines
IL-1 beta and TNF alpha - Local effects are swelling, darkening of tissue,
oedema and necrosis - In septicaemia, leads to increased vascular
permeability, haemorrhage, shock and death
17
Signal for macrophage activation switched to cell
death. May explain why host overwhelmed
18
Anthrax - Humans
- 3 forms of disease in man
- Cutaneous (malignant pustule) endospores enter
abraded skin septicaemia if untreated - Pulmonary woolsorters disease inhalation of
spores - Intestinal ingestion of infective material
- All fatal if not recognised early
- Bioterrorist weapon of choice!?
19
(No Transcript)
20
Anthrax - Control
- Do not open carcass as this will facilitate spore
formation and environmental contamination! - Report to regulatory authority
- Annual vaccination (endemic regions)
- Chemoprophylaxis (in outbreaks)
- Carcasses incinerated or buried away from water
courses - Contaminated material disinfected in 10 formalin
or if appropriate incinerated